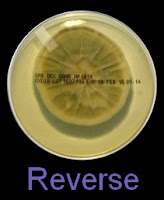
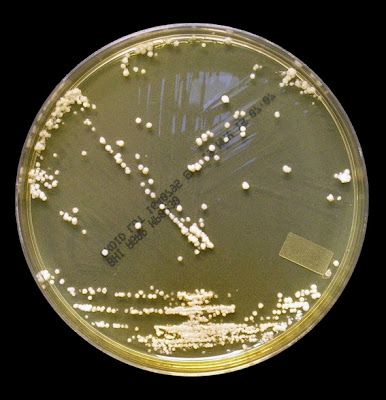

Sporothrix schenckii Complex –Hyphomycetes (Dimorphic Fungus)
Note1:I first added a post entitled Sporothrix schenckii back in November of 2008 while bedbound, recovering from a serious injury. I had just discovering ‘blogging’ and toyed with the idea of posting a few film photos that I had tucked away in a drawer – just for the fun of it. The poor quality photo demanded it be upgraded once I decided to keep up my blog ‘Fun with Microbiology’. Finally, here is the upgraded blog post, perhaps more accurately entitled Sporothrix schenckii complex Revisited.
Note2: In recent years, gene sequencing studies have revealed that the species previously known as Sporothrix schenckii is actually composed of several species. The currently accepted species names of the species which comprise the complex are as follows: S.albicans (formerly Sporothrix pallida), S.brasiliensis, S.globosa, S.luriei, S.mexicana, and S.schenckii , ‘sensu strictu’. As many clinical laboratories may not have routine access to molecular technology for specific speciation, this blog simply describes Sporothrix schenckii complex with macroscopic, microscopic and physiological features found in most current textbooks.
Ecology:
Sporothrix is a cosmopolitan (found just about everywhere) fungus which is commonly isolated from soil and decomposing plant matter. Peat moss is a particularly well known source of Sporothrix. It may also be found on living plants such as rose bushes leading to what has been termed ‘rose handler’s disease’ where the fungus gains entry to the host through thorny pricks.
Pathogenicity:
Sporothrix schenckii is the agent responsible for sporotrichosis, a chronic infection that most frequently begins as a skin puncture with introduction of the fungus into the subcutaneous tissues. Eventually it will involve the lymph nodes and lymphatic channels that drain the infected area. Implantation of the fungus is usually by puncture by items contaminated with plant material harbouring the fungus such as wood splinters, sphagnum moss, hay or thorns as previously mentioned. Pulmonary (respiratory) infection may also develop in predisposed individuals after inhaling fungal spores. Rare cases of disseminated Sporothrix infection with a fatal outcome have been reported.
Laboratory acquired infections have also been reported.
Sporothrix schenckii is a thermally dimorphic fungus, meaning it can take on one of two forms depending on the temperature it finds itself in.
· At 25ᵒC exhibits the mould (filamentous) form, with a glabrous, moist texture. Initially white or cream coloured, the colony may acquire a black colour with aging
· At 37ᵒC exhibits a yeast-like form, with a creamy texture, cream to beige in colour.
Macroscopic Morphology:
The mould or filamentous phase in greater detail:
Growth is described by most sources s moderately rapid to rapid, with the colony becoming mature within 7 days.
The filamentous phase grown on SAB or PDA is generally cream coloured with some sources describing orange to orange-grey colouration. As the fungus matures, a salt & peppery brown or black colour develops with the colony retaining a narrow whitish border. Isolates may vary in their colour, some being dark/black from initial growth. Stock cultures kept for long periods may lose their dark colour completely.
The reverse of darkly pigmented colonies is usually dark in the center with a progressively lighter periphery.
Sporothrixinitially has a moist appearance but becomes wrinkled and leather to velvety in texture as it ages.
Sporothrix schenckii - SAB, 30ᵒC, 3 weeks incubation (Nikon)
The Yeast Phase:
The yeast phase is best induced by growing the fungus on Brain-Heart Infusion (BHI) agar at 37ᵒC, and observing after several generations (subcultures). At 37ᵒC, Sporothrix exhibits a yeast-like form, with a creamy texture, cream to beige in colour which also may darken with aging.
(Yeast Phase Photo further below)
Microscopic Morphology:
Fillamentous Mould Phase:
Sporothrixproduces narrow (1 – 2 µm dia.) hyaline, septate and branching hyphae.
Sporothrixproduces two types of conidia:
· Slender, tapering conidiophores arise at right angles from undifferentiated hyphae. Hyaline conidia are produced at a small swelling at the conidiophores apex by sympodial growth resulting in a “rosette-like” appearance. These conidia (2 – 3 X 3 – 6 µm) are tear-drop shaped to round in appearance and unless disturbed, remain attached to the conidiophore in young cultures via thread-like denticles. (Rosette)
· Single thick-walled brown to black (dematiaceous) sessile conidia (2 – 4 µm dia.) can also be present, arising directly from the hyphae.
Sporothrix schenckii -Initial look at the growth attached to a cover slip from a slide culture.
(100X, LPCB, DMD-108)
Sporothrix schenckii - A closer look where detail begins to emerge.
(400X, LPCB, DMD-108)
Sporothrix schenckii - ditto
(400X, LPCB, DMD-108)
Sporothrix schenckii - At yet a higher magnification, fine structures emerge. Conidia are easily seen at the tips of conidiophores. At the center of this photo one such structure is seen in a 'rosette' arrangement, typical for this fungus.
(1000X, LPCB, DMD-108)
Sporothrix schenckii - hyphae bearing conidiophores with conidia being produced sympodially at the apex. (1000X, LPCB, DMD-108)
Sporothrix schenckii - appearing somewhat in 3-D, the hypha is seen running across the photo with conidiophores extending at right angles from the hypha. Conidia formation is is seen at different stages with the conidiophore at the right having accumulated numerous conidia.
(1000X, LPCB. DMD-108)
Sporothrix schenckii - again in "3-D" perspective, you can see a number of hyphae below, and out of the plane of focus of the camera, bearing conidiophores which appear to be rising upwards, towards the camera/viewer. Conidia are present at the apex.
(1000X, LPCB, DMD-108)
Sporothrix schenckii -septate hyphae are show and two well defined conidiophores are shown with a 'rosette' of conidia at the apex.
(1000+10X, LPCB, DMD-108)
Sporothrix schenckii -another look at the conidiophores with conidia accumulated at the apex (tips). Fine thread-like denticles can be seen attaching the ellipsoid or tear drop shaped conidia to the conidiophore.
(1000+10X, LPCB, DMD-108)
Sporothrix schenckii -yet another view, as above.
(1000+10X. LPCB, DMD-108)
Sporothrix schenckii -what is meant as a "rosette" configuration of conidia. This is typical of Sporothrix schenckii and assists in its identification.
(1000+10X, LPCB, DMD-108)
Sporothrix schenckii - I particularly like this photo. Like a shower of delicate flowers. What is seen are the conidia rosettes at the tips of unseen conidiophores and hyphae, below the plane of focus. (1000X, LPCB, DMD-108)
Sporothrix schenckii -a single hypha running through the photo, bearing conidia in typical rosette pattern. (1000X, LPCB, DMD-108)
Sporothrix schenckii -single, sessile and begining to show dark pigment (dematiaceous), are seen along the hypae. (1000X, LPCB, DMD-108)
Sporothrix schenckii -ditto. Black pigment much more pronounced in this photo.
(1000X, LPCB, DMD-108)
Sporothrix schenckii - again, as above.
(1000+10X, LPCB, DMD-108)
Sporothrix schenckii - just another photo...
(1000+10X, LPCB, DMD-108)
Sporothrix schenckii -Sessile (attached directly to hypha) with many developing a dark pigmentation (dematiaceous) which gives the macroscopic colony its distinctive colour.
(1000X, LPCB, DMD-108)
Sporothrix schenckii - dematiaceous cells are more abundantly produced as the colony ages.
(1000X, LPCB, DMD-108)
Sporothrix schenckii -sessile dematiaceous conidia are seen lining a hypha running through the photo, as well as some conidiophores bearing the tear-drop shaped conidia.
(1000X, LPCB, DMD-108)
Sporothrix schenckii -another view of the sessile, dematiaceous conidia lining the hypha with a few conidiophores extending from the hypha showing the delicate rosette arrangement at the tips. (1000X, LPCB, DMD-108)
Sporothrix schenckii -and just another photo showing what was described in the last few photos.
(1000X, LPCB, DMD-108)
Sporothrix schenckii -a nice rosette formation in the center of the photo.
(1000+10X, LPCB, DMD-108)
The Yeast Phase:
As previously mentioned, the yeast phase is best induced by growing the fungus on Brain-Heart Infusion (BHI) agar at 37ᵒC, and observing after several generations (subcultures). Yeast cells are round to ovoid of varying size (1 – 3 X 3 – 10 µm), producing single or multiple buds often resembling rabbit ears or ‘Mickey Mouse’ ears extending from the primary yeast cell.
Sporothrix schenckii -the very same organism added to the nutritionally rich Brain-Heart Infusion (BHI) agar and incubated at 37ᵒC for ten days. A typical pasty, yeast form develops which is why this organism is 'dimorphic'. (Nikon)
Sporothrix schenckii -yeast cells seen in a suspension in Lactophenol Cotton Blue.
(1000+10X, LPCB, DMD-108)
Sporothrix schenckii - Sporothrix in the yeast phase may show single yeas like cells with some of the population budding with typical "rabbit ears" or "Mickey Mouse" ears. They appear as two elongated cells projecting from the same surface of the parent cell. One can be seen here, one-third in from the center left edge of the photo. (1000X, LPCB, DMD-108)
Sporothrix schenckii -"Mickey Mouse' ear configuration in the cell at the upper center.
(1000X, LPCB, Nikon)
Sporothrix schenckii -again, yeast cells with two attached daughter cells on the same side giving the apearance of "rabbit ears" or "Mickey Mouse" ears.
(1000+10X, LPCB, DMD-108)
Sporothrix schenckii -ditto (as above) -inset -floppy 'rabbit ears"
(1000X, LPCB, DMD-108)
Sporothrix schenckii - that's it, I'm done!
(1000+10X, LPCB, DMD-108)
Physiology:
Sporothrix is resistant to cycloheximide; however growth is inhibited at temperatures of 39 - 40ᵒC.
* * *